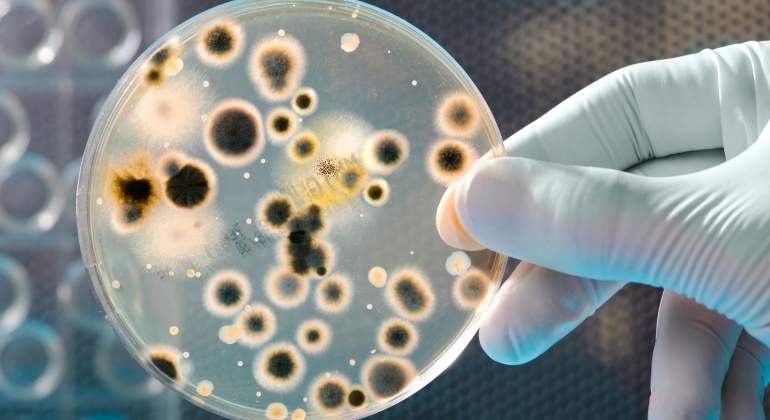
bacterias-dreamstime.jpg

Işın Erenoğlu
TÜRKİYE EKONOMİSİNİ BAKTERİLER KURTARABİLİR Mİ?
Madencilikte bakteriler kullanılabilir mi? Dünyada bunun örnekleri var mı? Bu yöntemle geleneksel yöntemlere nazaran ne kadar kazanç sağlanır? Ya da esas soru Türkiye’de bakteriler nasıl paraya çevrilir?

Yukarıdakileri okuyunca, çoğu kişinin aklına belki de simya geldi ama Türkiye’deki madencilikte bakteriyle ayrıştırma yöntemi kullanarak, ekonomimizi düzeltmemiz mümkün, üstelik doğaya zarar vermeden!
Sebebine gelince, Türkiye, maden rezervi bakımından oldukça zengin bir ülke ve insanlığın, ilk çağlardan beri kullandığı metaller, günümüzde elektrik kablolarından, telefon hatlarına, mücevherlere kadar bizlere her an değişen kullanım alanlarını artarak sunmaya devam ediyor.
Konuyla ilgili şuanda ülkemizde uygulanan, geleneksel yöntem nedir derseniz;
Çoğunlukla yer altında bulunan, içinde madenin bulunduğu kaya parçalarına ‘’Cevher’’ denir. İlgili madenin cevherden ayrılarak, saflaştırılması için, çok yüksek enerji maliyetleri veya doğaya zararlı olabilecek kimyasal işlemler (siyanür gb.) gereklidir.
İlk olarak Sondaj yapılır ve belirli derinlikten geçen maden damarı bulunur. Sonra dinamitle patlatılarak yada kırıcıyla kaya parçalanarak, cevherler toplanıp yeryüzüne çıkarılır. Çıkarılan cevherler, öğütülerek ufak parçalar haline getirilir ve içlerindeki maden ayrıştırılmak üzere, çok yüksek ısı yada toksik kimyasallara maruz bırakılır. Böylece saf maden, cevherden ayrıştırılmaya çalışılır. Ülkemizde uygulanan en yaygın geleneksel yöntem budur.
İşte tam bu noktada bakteriler sancağı devralıyor, Nasıl mı?
Geleneksel madencilikte, esas enerji giderini oluşturan ve doğaya zarar veren toksik kimyasalların kullanıldığı ayrıştırma işlemini bertaraf etmek için dünyada bakteri madenciliği kullanılıyor.
Geleneksel madencilikte, esas enerji giderini oluşturan ve doğaya zarar veren toksik kimyasalların kullanıldığı ayrıştırma işlemini bertaraf etmek için dünyada bakteri madenciliği kullanılıyor.
Bu yöntemi ilk kim buldu derseniz, 1947’de ABD’deki bilim adamları, bakırın Theobacillus ferrooxidans isimli bakteri tarafından ayrıştırıldığını keşfettiler.
Peki ticari anlamda ilk ne zaman bakteriler kullanıldı diye sorarsanız?
Belki şaşıracaksınız ama yaklaşık 50 sene önce, ilk kez 1970’lerde cevheri saflaştırmak için Kanada’da düşük kalitedeki uranyumu ayrıştırmak ve Günay Afrika’daki altını ayrıştırmak için bakteriler kullanıldı. 80’lerin ortasında ise ABD bakır endüstrisinin kurtarılmasında yine bakterilerden faydalanıldı[1].
Bakteri madenciliğinin tercih edilmesinin temel sebeplerinden bir diğeri de, cevherin saflık derecesidir. Biraz daha açıklayacak olursak,
O tarihte ABD’de artık yüksek bakır oranına sahip cevherin tükenmesi ve düşük oranda bakır içeren cevheri ayrıştırmanın geleneksel yöntemlerle çok pahalı kalması nedeniyle, sektör alternatif çözümlere yöneldi . Dolayısıyla ABD’de bakteri yöntemi ile ayrıştırma başladı. Böylece hem ayrıştırma işlemi için gereken maliyet çarpıcı oranda düşürülürken, alınan kararla da, Amerikan Çevre Koruma Ajansı, geleneksel bakır ayrıştırma yöntemiyle endüstride havaya salınan sülfür dioksit gazını durdurmuş oldu[1]. Daha net bir ifadeyle, Bakteri madenciliği kullanılarak, bakır fiyatının ABD’de %60 oranında düştüğünü yazarsak[1], bu biolojik yöntemin önemini daha iyi gözler önüne sermiş oluruz diye düşünüyorum.
Diğer taraftan, saflık derecesi düşük olan cevherin ayrıştırılması, geleneksel yöntemlerle çok pahalı olduğu için yapılamıyor ve bu sebeple bir ocaktaki madenlerin ancak %60’ı çıkarılabiliyorken, bakterilerin kullanımıyla, maliyet oldukça düştüğü için, düşük kalitedeki cevheri de işleyebilerek, artık bu oran, yani madenin çıkarılma oranı, %90’a çıkıyor.
Buraya kadar her şey iyi ama, bakteriler enerji kaynağı olarak ne kullanıyor diye sorabilirsiniz...
Biosigma şirketinin Arge müdürü Pilar Paddar’ın konuyla ilgili açıklamasına göre, Bakteriler; oksijen, karbondioksit ve madenin kendisini enerji ihtiyaçları için kullanıyor.
Bu yöntemin hiç dezavantajı yok mu dediğinizi duyar gibiyim,
Bakteri ile madencilik, genellikle bakır, nikel, uranyum, altın gibi sulfur içeren yataklarda uygulanmaktadır[3]. Bioleaching olarak adlandırılan bu işlemin süresi bazen günler alırken, bazen de aylar alabiliyor. Bu da bakterilerle madenciliğin tek dezavantajıdır diyebiliriz ama size burada ilginç bir örnek vermek isterim. Şili, bu dezavantaja rağmen ekonmisini bakteriyle, bakır madenciliği yaparak kalkındıran bir ülkedir ve daha da ötesi, dünyanın en büyük bakır ihracatçısıdır. Sayısal olarak ifade edecek olursak, Şili ihracatının %70’ini bakırdan, bakteri madenciliği ile sağlamaktadır.
Peki Türkiye’de madencilik nasıl derseniz,
Türkiye bakır ve krom cevheri başta olmak üzere, metal madenlerini büyük oranda işlemeden, düşük fiyatlı cevher olarak Çin ve diğer ülkelere satan bir ülke. Külçe formunda işlenen madeni ise, çok yüksek fiyatla büyük oranda Şili’den geri alıyor. Neden mi? Almanya başta olmak üzere, makine üreticisi ülkelerden aldığı metal işleme makineleriyle, dışarıdan yüksek bedellere satın aldığı külçeleri, bakır tel gibi endüstriyel ürünlere dönüştürmek ve ihraç etmek için. Dolayısıyla buradaki esas problem, Türkiye’nin cevheri kendine ait olmasına rağmen, enerji maliyetinin çok yüksek olması ve işleme teknolojisinin yetersiz kalması nedeniyle, yüksek karla kazanmak yerine, oldukça küçük bir kara razı gelmesinden kaynaklanmaktadır. Yüksek katma değerli üretim yapılamadığı için endüstrimiz ve ekonomimiz dışa bağımlı kalarak, ancak düşük kar marjlarından bahsedebiliyoruz. Oysa bakteri madenciliği uygulanarak, enerji tasarrufu yapılmakta, verim artışı sağlanmakta, malzeme kalitesi artmakta ve bunun yanında zararlı çevresel etkiler oldukça azaltılmaktadır.
Hal böyleyken, bu yöntemin yaklaşık 50 sene önce dünyada kullanılmaya başlanmasına rağmen, neden hala Türkiye'de kullanılmadığı sorusu kafaları karıştırmaya devam ediyor?
 Bakterilerin, sağladıkları faydalar nedeniyle, sadece madencilikte değil, elektronik vb. dünyadaki bir çok sektöre kullanımı yayılarak, devam ediyor.
Bakterilerin, sağladıkları faydalar nedeniyle, sadece madencilikte değil, elektronik vb. dünyadaki bir çok sektöre kullanımı yayılarak, devam ediyor.
Fikrimi sorarsanız, bakterileri, madencilikten daha fazla rağbet görecek, garanti bir sektörde kullanmak, talep patlamasına neden olabilir! ‘’Estetik Sektörü’’! Bir düşünsenize, bir bardak suyla bakterileri hoop yutuyorsunuz. (Nano robotların yapmasını planladıkları gibi ileride bedenin reaksiyon göstermeyeceği özel bakteri gruplarının kanda serbestçe dolaşabileceğini düşünün.) Neştersiz bir yöntemle, istemediğiniz bölgedeki yağlar hapur hupur yeniyor, göbek gibi... Sonra istediğiniz bir bölgeye tıkır tıkır taşınıyor! Kadınlarda Kim Kardashian marka oturma yastıklarına yada süt üretim tesislerine böylece depo yapmak mümkün! Silikon takılırken ki acı, sızı tarih olmuş. Gelsin ‘’bakteriyle şekillen’’ fırtınası! Üstelik su yerine, meşhur içecek firmalarının bakteriyle şekillen versiyonları çıkarsa pekala çifte kazanç da sağlanabilir. Bir de sloganda gelsin o zaman, İçelim Güzelleşelim!!!
Hayaller elbette sınırsız ama önce elimizdekilerin kıymetini bilip kullanmak dileğiyle...
Sevgiyle kalın!
Işın Erenoğlu Üstündağ
Referanslar:
[1]https://www.abc.net.au/science/kelvin/k2/trek/4wd/Over43.htm
[2]https://www.bbc.com/news/technology-17406375
[3]https://www.americangeosciences.org/critical-issues/faq/what-biomining
[4]https://www.medicalnewstoday.com/articles/319411.php









